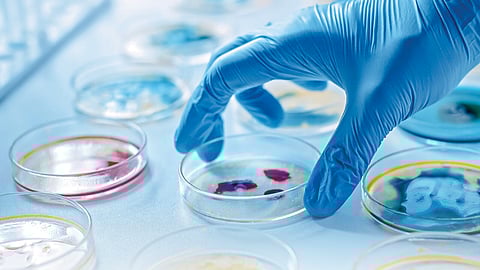

सूक्ष्मजीवशास्त्र ही शाखा कधी, कशी सुरू झाली... कशी विकसित झाली... आज तिचं स्थान काय आहे... कशा प्रकारे मानवजातीच्या विकासासाठी तिचा उपयोग करून घेण्यात येत आहे...
- डॉ. प्रगती अभ्यंकर apragati10@gmail.com
सूक्ष्मजीवशास्त्र ही शाखा कधी, कशी सुरू झाली... कशी विकसित झाली... आज तिचं स्थान काय आहे... कशा प्रकारे मानवजातीच्या विकासासाठी तिचा उपयोग करून घेण्यात येत आहे... या क्षेत्रातील संशोधनविकास, भारतातील या शास्त्राची आजची परिस्थिती... या सर्व गोष्टींचा आढावा आत्तापर्यंतच्या लेखांत घेण्यात आला.ज्यांना मुळातच जीवशास्त्राची आवड असते, विज्ञानाच्या या शाखेकडे वळून काहीतरी करायची - संशोधन अथवा नोकरी किंवा त्याच्याशी संलग्न काहीतरी उद्योग करायची - इच्छा असते अशा सर्व विद्यार्थ्यांसाठी आजचा हा लेख...
स्वतःच्या मुलांनी जर हा विषय निवडला तर त्यांचं भवितव्य काय असेल, याविषयी पालकही संभ्रमात असतात. या शाखेकडे वळून त्यात भवितव्य घडवायला खूप संधी, अनेक वाटा आहेत. या विषयाची व्याप्ती खूप मोठी आहे. आपल्याकडे दहावीची परीक्षा झाल्यावर पुढं शास्त्रशाखेची निवड करून तीत जीवशास्त्र हा विषय अवश्य निवडावा. त्यापुढं बारावीनंतर पदवीचं शिक्षण घेण्यासाठी सूक्ष्मजीवशास्त्र हा विषय घ्यावा. बहुतेक विद्यापीठांतून पदवीच्या पहिल्या वर्षापासून हा विषय असतो. याबरोबर बाकीचे विषय कुठले निवडायचे हे थोडंसं आपण प्रवेश घेत असलेल्या महाविद्यालयावर अवलंबून असतं. त्याप्रमाणे सुसंगत विषय निवडून सूक्ष्मजीवशास्त्र या विषयात पदवी प्राप्त करावी.
यापुढची पायरी म्हणजे, या विषयातील पदव्युत्तर शिक्षण. काळानुरूप यात अनेक बदल झाले आहेत. बरेच विद्यार्थी सूक्ष्मजीवशास्त्रातील पदवी प्राप्त करून मग या विषयाशी संलग्न अन्य विषयांत पदव्युत्तर शिक्षण घेण्यास प्राधान्य देतात. यात जैवतंत्रज्ञान (Biotechnology), जैवमाहिती तंत्रज्ञान (Bioinformatics), अन्नतंत्रज्ञान (Food Technology), जैवविविधता (Biodiversity), पर्यावरणशास्त्र (Environmental Science) व गर्भशास्त्र (Embryology) हेही पर्याय निवडतात. बदलत्या गरजांनुसार, हे विषयही महत्त्वाचे ठरत आहेत.
सूक्ष्मजीवशास्त्रातील पदव्युत्तर शिक्षण घेताना आपण निवडत असलेलं विद्यापीठ, महाविद्यालय यासंदर्भात काही बाबींची खातरजमा करून घ्यावी. बहुतेक ठिकाणी प्रवेशपरीक्षा घेतली जाते व तीत मिळालेल्या गुणांवरून प्रवेश निश्चित केला जातो, तसंच पदवीपरीक्षेत मिळालेले गुण हे बहुतेक ठिकाणी धरले जातात.
पदव्युत्तर शिक्षण पूर्ण करत असताना अखेरच्या सत्रात एखादा छोटा प्रकल्प (Project) पूर्ण करून प्रबंध लिहिणं (Dessertation) हे अभ्यासक्रमात समाविष्ट असतं. यासाठी योग्य विषय निवडावा व उत्तम काम करावं; ज्यायोगे पुढं नोकरी मिळण्याच्या दृष्टीनं उपयोग होईल. ज्या विद्यार्थ्यांना पुढं संशोधनक्षेत्रात जायचं नाही त्यांना उत्तम नोकरीसाठी याचा खूप उपयोग होतो असा माझा अनेक वर्षांचा अनुभव आहे.
पदव्युत्तर शिक्षण पूर्ण केलेल्या विद्यार्थ्यांना नोकरीच्या संधी उपलब्ध असणारी अशी अनेक क्षेत्रं आहेत. यात पॅथॉलॉजी प्रयोगशाळा (Pathology Lab), अन्नशास्त्र प्रयोगशाळा (Food Science Lab), वैद्यकीय तंत्रज्ञान (Medical Technologist), आरोग्यशास्त्रज्ञ(Health Scientist), जलगुणवत्ता विश्लेषणतंत्रज्ञ (Water Quality Analysis Technician), चिकित्सासंशोधन तंत्रज्ञ (Clinical Research Scientist), औषधनिर्माण शास्त्रज्ञ (Pharmacologist), किण्वनप्रक्रियातज्ज्ञ (Fermentation Technologist), जैवतंत्रज्ञ (Biotechnologist), पर्यावरणशास्त्रज्ञ (Ecologist), न्यायवैद्यकतज्ज्ञ (Forensic Scientist), सागरी सूक्ष्मजीवतज्ज्ञ (Marine Microbiologist). याशिवायही, सूक्ष्मजीवशास्त्रात पदव्युत्तर शिक्षण घेतलेल्या विद्यार्थ्यांना संधी उपलब्ध असणारी अनेक क्षेत्रं आहेत.
अलीकडे Dry Lab ही संकल्पना चांगलीच मूळ धरू लागली आहे. तीत प्रत्यक्षात प्रयोगशाळेत काम करण्याऐवजी संगणकावर ती प्रक्रिया करून निष्कर्ष काढले जातात. यामुळे प्रत्यक्ष प्रयोगशाळेतील अनेक धोके टाळता येतात. अशा Dry Labs मध्ये सूक्ष्मजीवशास्त्रातील पदव्युत्तर शिक्षण घेतलेल्यांना नोकरीच्या चांगल्या संधी उपलब्ध आहेत.
अर्थात्, चांगली नोकरी मिळवण्यासाठी मूळ पदवीच्या पलीकडेही काही गोष्टी आत्मसात करणं गरजेचं असतं. यात मुलाखतीचं तंत्र, नोकरीसाठी लागणारी काही कौशल्यं, थोडं विशिष्ट प्रकारचं प्रशिक्षण, यांचा समावेश आहे.
बऱ्याच विद्यार्थ्यांना पदव्युत्तर शिक्षणानंतर नोकरीकडे न वळता संशोधन करायचं असतं. त्यासाठी भारतात सीएसआयआर नेट (CSIR NET) ही परीक्षा उत्तीर्ण होणं आवश्यक असतं; ज्यायोगे चांगल्या संशोधनसंस्थांमधून पीएच. डी. होण्याची संधी मिळू शकते, तसंच शिष्यवृत्तीही उपलब्ध होऊ शकते. अशा अनेक संशोधनसंस्थांचा उल्लेख गेल्या लेखात मी केला आहे. यापलीकडे विद्यापीठातून किंवा संलग्न महाविद्यालयांच्या मान्यताप्राप्त संशोधनकेंद्राकडून पीएच.डीच्या संधी उपलब्ध असतात. यासाठी त्या विद्यापीठांची पीएच.डी. प्रवेशपरीक्षा उत्तीर्ण होणं आवश्यक असतं, तसंच पुढची सर्व प्रक्रिया करणंही आवश्यक असतं. चांगल्या दर्जाचं पीएच.डीचं संशोधन, चांगल्या संशोधनपरिषदांमधून स्वतःचं काम प्रकाशित करणं,चांगल्या संशोधनपत्रिकांमधून संशोधननिबंध प्रकाशित करणं, पेटंट मिळवणं यांद्वारे संशोधनक्षेत्रातील पुढील वाटचाल यशस्वी व आनंददायी होऊ शकते. पीएच. डी. ही विद्यापीठ, महाविद्यालय व संशोधन व विकाससंस्थांमध्ये नोकरी मिळवण्यासाठीची मूलभूत पदवी आहे. त्यासाठी अथक् परिश्रम हाच मंत्र आहे. अनेक विद्यार्थी सूक्ष्मजीवशास्त्राचं शिक्षण घेऊन स्वतःचा उद्योग सुरू करू इच्छितात. त्यासाठी वेगळं नियोजन, आर्थिक पाठबळ व थोडी वेगळी मनोवृत्ती व जिद्द लागते; परंतु या सगळ्यांचा योग्य समन्वय साधून यशस्वी उद्योजक होणाऱ्यांची संख्याही वाखाणण्याजोगी आहे.
हे सर्व बघता, या विषयात करण्यासारखं खूप काही आहे. अनेक पर्याय आहेत. स्वतःच्या आवडीला परिश्रमांची जोड देऊन योग्य मार्गदर्शन घेऊन हा प्रवास निश्चितच आनंददायी व यशस्वी होऊ शकेल ही खात्री आहे.
(लेखिका सूक्ष्मजीवशास्त्राच्या प्राध्यापिका आहेत)
सकाळ+ चे सदस्य व्हा
ब्रेक घ्या, डोकं चालवा, कोडे सोडवा!
शॉपिंगसाठी 'सकाळ प्राईम डील्स'च्या भन्नाट ऑफर्स पाहण्यासाठी क्लिक करा.
Read latest Marathi news, Watch Live Streaming on Esakal and Maharashtra News. Breaking news from India, Pune, Mumbai. Get the Politics, Entertainment, Sports, Lifestyle, Jobs, and Education updates, मराठी ताज्या बातम्या, मराठी ब्रेकिंग न्यूज, मराठी ताज्या घडामोडी. And Live taja batmya on Esakal Mobile App. Download the Esakal Marathi news Channel app for Android and IOS.